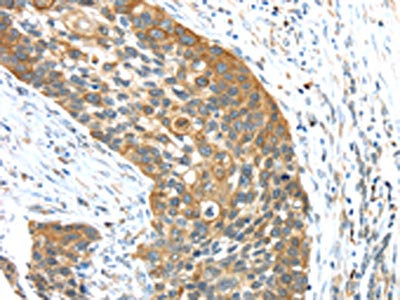

TRIM16 Antibody
-
中文名稱:TRIM16兔多克隆抗體
-
貨號(hào):CSB-PA436403
-
規(guī)格:¥1100
-
圖片:
-
The image on the left is immunohistochemistry of paraffin-embedded Human liver cancer tissue using CSB-PA436403(TRIM16 Antibody) at dilution 1/35, on the right is treated with fusion protein. (Original magnification: ×200)
-
The image on the left is immunohistochemistry of paraffin-embedded Human esophagus cancer tissue using CSB-PA436403(TRIM16 Antibody) at dilution 1/35, on the right is treated with fusion protein. (Original magnification: ×200)
-
-
其他:
產(chǎn)品詳情
-
Uniprot No.:
-
基因名:TRIM16
-
別名:EBBP antibody; Estrogen responsive B box protein antibody; Estrogen-responsive B box protein antibody; TRI16_HUMAN antibody; TRIM 16 antibody; TRIM16 antibody; Tripartite motif containing 16 antibody; Tripartite motif containing protein 16 antibody; Tripartite motif-containing protein 16 antibody
-
宿主:Rabbit
-
反應(yīng)種屬:Human,Mouse
-
免疫原:Fusion protein of Human TRIM16
-
免疫原種屬:Homo sapiens (Human)
-
標(biāo)記方式:Non-conjugated
-
抗體亞型:IgG
-
純化方式:Antigen affinity purification
-
濃度:It differs from different batches. Please contact us to confirm it.
-
保存緩沖液:-20°C, pH7.4 PBS, 0.05% NaN3, 40% Glycerol
-
產(chǎn)品提供形式:Liquid
-
應(yīng)用范圍:ELISA,IHC
-
推薦稀釋比:
Application Recommended Dilution ELISA 1:2000-1:5000 IHC 1:25-1:100 -
Protocols:
-
儲(chǔ)存條件:Upon receipt, store at -20°C or -80°C. Avoid repeated freeze.
-
貨期:Basically, we can dispatch the products out in 1-3 working days after receiving your orders. Delivery time maybe differs from different purchasing way or location, please kindly consult your local distributors for specific delivery time.
-
用途:For Research Use Only. Not for use in diagnostic or therapeutic procedures.
相關(guān)產(chǎn)品
靶點(diǎn)詳情
-
功能:E3 ubiquitin ligase that plays an essential role in the organization of autophagic response and ubiquitination upon lysosomal and phagosomal damages. Plays a role in the stress-induced biogenesis and degradation of protein aggresomes by regulating the p62-KEAP1-NRF2 signaling and particularly by modulating the ubiquitination levels and thus stability of NRF2. Acts as a scaffold protein and facilitates autophagic degradation of protein aggregates by interacting with p62/SQSTM, ATG16L1 and LC3B/MAP1LC3B. In turn, protects the cell against oxidative stress-induced cell death as a consequence of endomembrane damage.
-
基因功能參考文獻(xiàn):
- High TRIM16 expression is associated with drug resistance in Non-Small Cell Lung Cancer. PMID: 29295721
- TRIM16 inhibits the migration and invasion via suppressing the Sonic hedgehog signaling pathway in ovarian cancer cells. PMID: 27737724
- The cooperation between TRIM16 and Galectin-3 in targeting and activation of selective autophagy protects cells from lysosomal damage and Mycobacterium tuberculosis invasion. PMID: 27693506
- TRIM16 expression is decreased in prostate cancer tissues and overexpression of TRIM16 inhibits cell migration, invasion and the EMT process in vitro in prostate cancer through the transcription factor Snail. PMID: 27748839
- Results found that the expression of TRIM16 was significantly downregulated in hepatocellular carcinoma cell (HCC) lesions and define TRIM16 as an inhibitor of epithelial-mesenchymal transition and metastasis in HCC. PMID: 26892350
- TRIM16 directly regulated the degradation of Gli1 protein via the ubiquitinproteasome pathway. TRIM16 expression was low in breast cancer. It negatively correlated with metastasis and suppressed stem-cell properties in breast cancer cells. PMID: 26718507
- Data suggest that TRIM16 and TDP43 are both good prognosis indicators; data shows that TRIM16 inhibits cancer cell viability by a novel mechanism involving interaction and stabilisation of TDP43 with consequent effects on E2F1 and pRb proteins. PMID: 26902425
- Expression of SDMGC and TRIM16 was upregulated in the distant metastasis tissues PMID: 25866896
- Chromatin immunoprecipitation assays revealed TRIM16 directly bound the IFNbeta1 gene promoter. Low level TRIM16 expression in 91 melanoma patient samples, strongly correlated with lymph node metastasis, and, predicted poor patient prognosis. PMID: 25333256
- results suggest that TRIM16 is a potential pharmacologic target for the treatment of NSCLC and promotion TRIM16 expression might represent a novel strategy to NSCLC metastasis PMID: 25843803
- TRIM16 can promote apoptosis by directly modulating caspase-2 activity in cancer cells. PMID: 23404198
- data suggest that TRIM16 acts as a novel regulator of both neuroblastoma G 1/S progression and cell differentiation PMID: 23422002
- via its unique structure, TRIM16 possesses both heterodimerization function with other TRIM proteins and also has E3 ubiquitin ligase activity. PMID: 22629402
- TRIM16 acts as a tumour suppressor, affecting neuritic differentiation, cell migration and replication through interactions with cytoplasmic vimentin and nuclear E2F1 in neuroblastoma cells. PMID: 20729920
- role in regulating keratinocyte differentiation PMID: 11919186
- These results provide evidence for a role of EBBP in innate immunity by enhancing the alternative secretion pathway of IL-1beta. PMID: 16575408
- EBBP increased betaRARE-transactivating function through its coiled-coil domain PMID: 16636064
- The estrogen-responsive B box protein (EBBP) restores retinoid sensitivity in retinoid-resistant cancer cells via effects on histone acetylation. PMID: 19147277
顯示更多
收起更多
-
亞細(xì)胞定位:Cytoplasm.
-
蛋白家族:TRIM/RBCC family
-
組織特異性:Highest levels found in testis, ovary, small intestine, colon, placenta, heart, skeletal muscle and mammary gland. More highly expressed in the fetus than in the corresponding adult tissues. Expressed in basal keratinocytes.
-
數(shù)據(jù)庫(kù)鏈接:
Most popular with customers
-
-
YWHAB Recombinant Monoclonal Antibody
Applications: ELISA, WB, IHC, IF, FC
Species Reactivity: Human, Mouse, Rat
-
Phospho-YAP1 (S127) Recombinant Monoclonal Antibody
Applications: ELISA, WB, IHC
Species Reactivity: Human
-
-
-
-
-